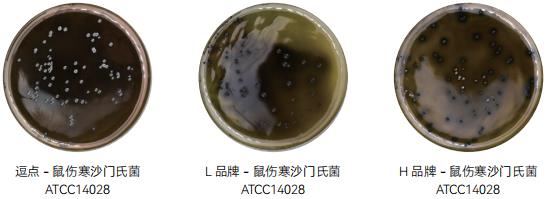
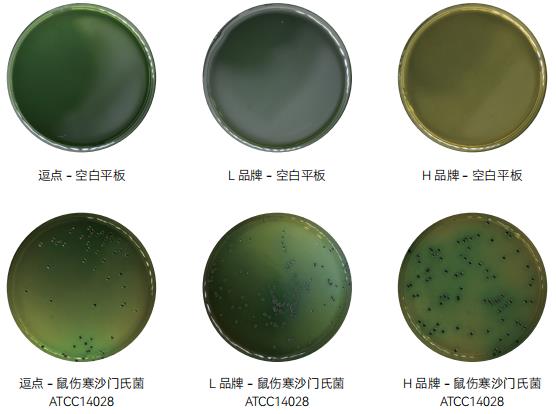
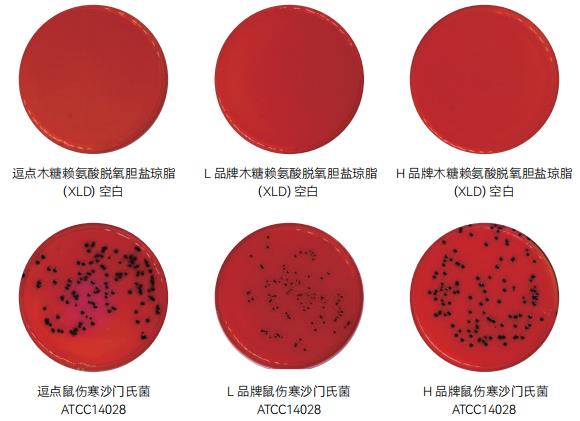
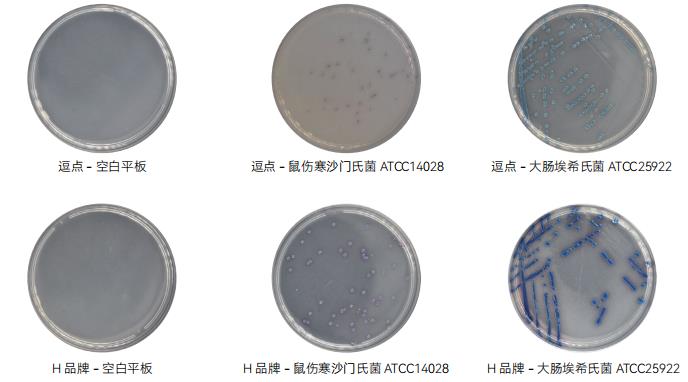
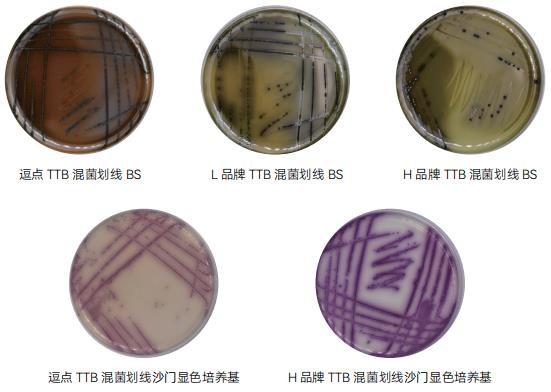
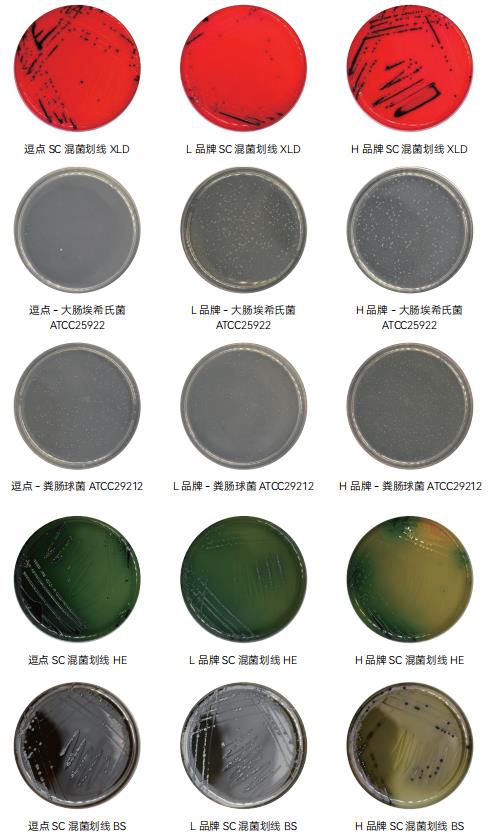
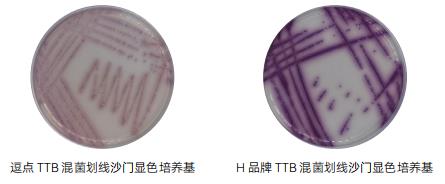
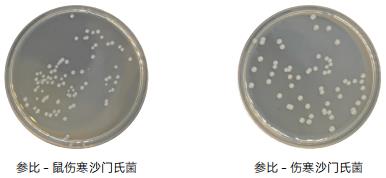
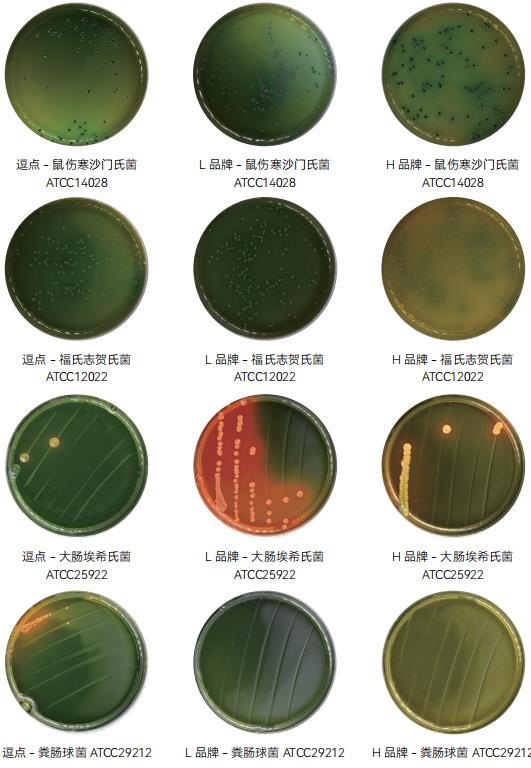
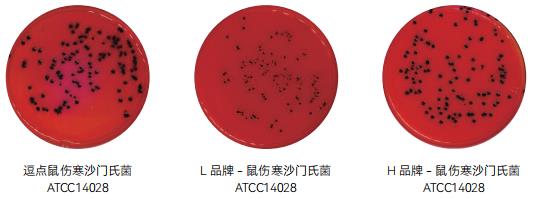
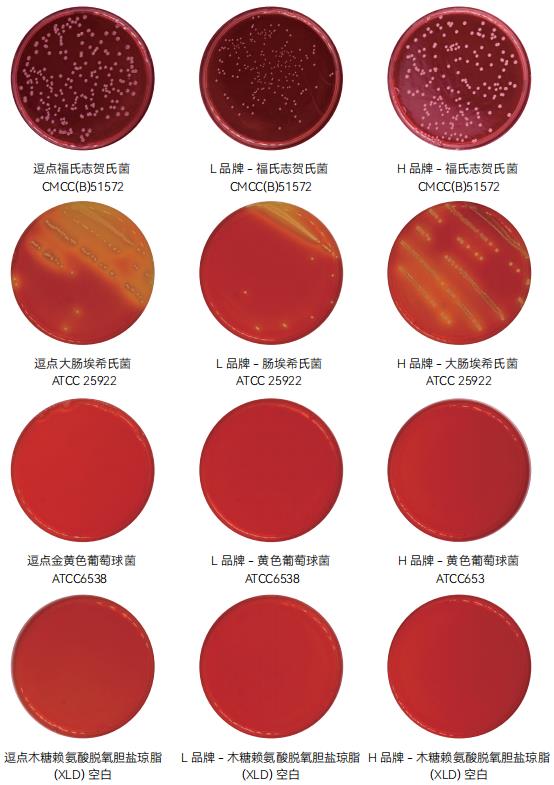

4、典型特征图片:


5、验证结果小结:
1、生长率:目标菌鼠伤寒沙门氏菌 ATCC14028、伤寒沙门氏菌 CMCC50071,逗点、L 品牌、H 品牌均满足国标PR≥0.5 的要求,鼠伤寒沙门氏菌 ATCC14028 生长率 L 品牌比逗点、H 品牌高,伤寒沙门氏菌 CMCC50071H 品牌生长率较低;
2、选择性:大肠埃希氏菌 ATCC25922:逗点、L 品牌、H 品牌平板均有菌落生长,逗点 G=2,选择性稍差,L 品牌 G=1, 选择性满足国标 G≤1 的要求,H 品牌 G=4,选择性不满足国标 G≤1 的要求,三家相比较 H 品牌大肠埃希氏菌选择性最差;粪肠球菌 ATCC29212:逗点、L 品牌、H 品牌未生长,都满足国标 G≤1 的要求;目前研发正在修改配方,新配方即将上市。
3、感观:逗点空白平板颜色比 L 品牌稍微偏深一点,沉淀较少,L 品牌空白平板颜色较浅,沉淀较明显,H 品牌空白平板颜色较深,无沉淀。
HE 琼脂验证

1、产品用途:用于肠道致病菌特别是沙门氏菌和志贺氏菌的选择性分离培养。
2、检验原理:蛋白胨、牛肉膏粉提供碳源、氮源、维生素和矿物质;乳糖、蔗糖和水杨素为可发酵的糖类;胆盐、去氧胆酸钠、溴麝香草酚兰和酸性复红抑制革兰氏阳性菌;氯化钠维持均衡的渗透压;硫代硫酸钠和柠檬酸铁铵用于检测硫化氢的产生,使菌落中心呈黑色;琼脂是培养基的凝固剂;溴麝香草酚兰和酸性复红为pH 指示剂,发酵糖产酸的菌落呈橙 - 黄色,不发酵糖的菌落为蓝绿色。
3、HE 琼脂验证
| 样品名称 |
质控菌株 |
厂家 |
待测培养基计数 |
菌液浓度计数(TSA) |
生长率(或特征) |
评定标准 |
结果判定 |
HE 琼脂 |
鼠伤寒
沙门氏菌
ATCC14028 |
逗点 |
58 |
76 |
0.7 |
PR≥0.5 |
符合 |
| L 品牌 |
81 |
1.0 |
符合 |
| H 品牌 |
56 |
0.7 |
符合 |
福氏志
贺氏菌
ATCC12022 |
逗点 |
117 |
142 |
0.8 |
PR≥0.5 |
符合 |
| L 品牌 |
135 |
0.9 |
符合 |
| H 品牌 |
142 |
1.0 |
符合 |
大肠埃
希氏菌
ATCC25922 |
逗点 |
/ |
/
/
/ |
G=0 |
G≤5 |
符合 |
| L 品牌 |
/ |
G=3 |
符合 |
| H 品牌 |
/ |
G=1 |
符合 |
| 粪肠球菌 ATCC29212 |
逗点 |
/ |
/
/
/ |
0.5 |
G≤1 |
符合 |
| L 品牌 |
/ |
G=0 |
符合 |
| H 品牌 |
/ |
G=0 |
符合 |
1. 鼠伤寒沙门氏菌 ATCC14028 在 HE 琼脂板上的菌落特征:绿 - 蓝色菌落,有黑心;
2. 福氏志贺氏菌 ATCC12022 在 HE 琼脂板上的菌落特征:绿 - 蓝色菌落
3. 大肠埃希氏菌 ATCC25922 在 HE 琼脂板上的菌落特征:选择性 G<5,橙红色菌落,可有胆酸沉淀; 4. 粪肠球菌 ATCC29212 在 HE 琼脂板上的菌落特征:选择性 G≤1; |
4、典型特征图片:


5、验证结果小结:
1、生长率:目标菌鼠伤寒沙门氏菌 ATCC14028、福氏志贺氏菌 ATCC12022,逗点、L 品牌、H 品牌均满足国标PR≥0.5 的要求,鼠伤寒沙门氏菌 ATCC14028、福氏志贺氏菌 ATCC12022L 品牌生长率均比逗点高。
2、选择性:大肠埃希氏菌 ATCC25922,逗点、L 品牌、H 品牌平板均有菌落生长,逗点相比其他两家选择性较强,都满足国标 G<5 的要求,粪肠球菌 ATCC29212,逗点平板上有微弱生长,L 品牌、H 品牌未生长,都满足国标G≤1 的要求;
3、感观:L 品牌平板颜色较深,H 品牌平板颜色偏淡绿,逗点颜色在两家之间;
木糖赖氨酸脱氧胆盐琼脂 (XLD) 验证

1. 产品用途:用于沙门氏菌、志贺氏菌的分离培养。
2. 检验原理:酵母膏粉提供氮源、维生素、生长因子;氯化钠维持均衡的渗透压;木塘、乳糖、蔗糖为可发酵糖类,产酸使酚红指示剂变黄;去氧胆酸钠抑制革兰氏阳性菌,但不影响沙门氏菌的生长;硫代硫酸钠可被某些细菌还原硫化氢,与柠檬酸铁铵中的铁盐生成黑色硫化铁;琼脂是培养基的凝固剂;酚红为 pH 指示剂。
| 样品名称 |
质控菌株 |
厂家 |
待测培养基计数 |
菌液浓度计数(TSA) |
生长率(或特征) |
评定标准 |
结果判定 |
木糖赖氨
酸脱氧
胆盐琼脂
(XLD) |
鼠伤寒
沙门氏菌
ATCC14028 |
逗点 |
125 |
102 |
PR=1.2 |
PR≥0.5 |
符合 |
| L 品牌 |
84 |
PR=0.8 |
符合 |
| H 品牌 |
139 |
PR=1.4 |
符合 |
福氏志
贺氏菌
ATCC12022 |
逗点 |
209 |
203 |
PR=1.1 |
PR≥0.5 |
符合 |
| L 品牌 |
172 |
PR=0.8 |
符合 |
| H 品牌 |
193 |
PR=0.9 |
符合 |
大肠埃
希氏菌
ATCC25922 |
逗点 |
/ |
/
/
/ |
G=3.5 |
G<5 |
符合 |
| L 品牌 |
/ |
G=1 |
符合 |
| H 品牌 |
/ |
G=5.5 |
不符合 |
金黄色
葡萄球菌 ATCC6538 |
逗点 |
/ |
/
/
/ |
G=0 |
G≤1 |
符合 |
| L 品牌 |
/ |
G=0 |
符合 |
| H 品牌 |
/ |
G=0 |
符合 |
1. 鼠伤寒沙门氏菌 ATCC14028 在 XLD 板上的菌落特征:黑色菌落;
2 福氏志贺氏菌 CMCC(B)51572 在 XLD 板上的菌落特征:无色菌落,无黑心;
3. 大肠埃希氏菌 ATCC 25922 在 XLD 板上的菌落特征:黄色菌落,选择性 G<5
4. 金黄色葡萄球菌 ATCC6538 在 XLD 上的菌落特征:选择性 G≤1; |
4、典型特征图片:


5、验证结果小结:
1. 生长率:目标菌鼠伤寒沙门氏菌 ATCC14028、福氏志贺氏菌 CMCC(B)51572 ,逗点、L 品牌、H 品牌均满足国标 PR≥0.7 的要求。H 品牌菌落生长速度更快,菌落特征更明显,L 品牌生长速度较缓慢;
2. 选择性:大肠埃希氏菌 ATCC 25922 ,逗点、H 品牌均满足国标G<5 的要求,H 品牌G=5.5 ,不满足国标要求;金黄色葡萄球菌 ATCC6538,逗点、L 品牌、H 品牌均满足国标G≤1 的要求;
3. 感观:三家平板颜色无显著差异。
4. 生长性能,逗点和 H 品牌优于 L 品牌。特异性上(特别是对大肠的抑制)L 品牌更好,逗点目前排第二。研发目前正在攻克对大肠的抑制。
沙门氏菌显色培养基验证

1、产品用途:用于沙门氏菌的分离和初步鉴定。
2、检验原理:蛋白胨和酵母膏粉提供氮源和微量元素, 氯化钠可维持均衡的渗透压,抑菌剂抑制革兰氏阳性菌,琼脂是培养基凝固剂;混合色素分别与沙门氏菌和大肠菌群所对应的酶发生特异性反应,水解底物,释放出显色基团,在淡黄色平板上沙门氏菌产生品红色的菌落,大肠菌群产生蓝绿色的菌落。
3、沙门氏菌显色培养基验证
| 样品名称 |
质控菌株 |
厂家 |
待测培养基计数 |
参比培养基计数(TSA) |
生长率(或特征) |
评定标准 |
结果判定 |
沙门氏菌
显色
培养基 |
鼠伤寒沙门氏菌 ATCC14028 |
逗点 |
45 |
76 |
0.5 |
PR≥0.5 |
符合 |
| H 品牌 |
64 |
0.8 |
PR≥0.5 |
符合 |
| 大肠埃希氏菌 ATCC25922 |
逗点 |
/ |
/ |
蓝色菌落 |
蓝色菌落 |
符合 |
| H 品牌 |
/ |
蓝色菌落 |
蓝绿色菌落 |
符合 |
| 奇异变形杆菌 CMCC(B)49005 |
逗点 |
/ |
/ |
无色,淡紫色 |
无色,淡褐色菌落 |
符合 |
| H 品牌 |
/ |
/ |
无色菌落 |
无色菌落 |
符合 |
粪肠球菌
ATCC29212 |
逗点 |
/ |
/ |
G=0 |
G≤1 |
符合 |
| H 品牌 |
/ |
/ |
G=0 |
符合 |
1. 鼠伤寒沙门氏菌 ATCC14028 在沙门氏菌显色培养基板上的菌落特征:品(紫)红色菌落; 2. 大肠埃希氏菌 ATCC25922 在沙门氏菌显色培养基板上的菌落特征:按说明书判定;
3. 奇异变形杆菌 CMCC(B)49005 在沙门氏菌显色培养基板上的菌落特征:按说明书判定;
4. 粪肠球菌 ATCC29212 在沙门氏菌显色培养基板上的菌落特征:选择性 G≤1; |
4、典型特征图片:


5、验证结果小结:
1、生长率:目标菌鼠伤寒沙门氏菌 ATCC14028,逗点满足国标 PR≥0.5 的要求,H 品牌满足说明书≥0.7 的要求;
2、特异性:大肠埃希氏菌 ATCC25922 逗点颜色浅蓝色,H 品牌颜色深蓝色;奇异变形杆菌 CMCC(B)49005: 逗点菌落无色,符合说明书要求,H 品牌菌落无色,符合说明书要求,生长较慢,逗点比 H 品牌生长较明显;
3、选择性:粪肠球菌 ATCC29212:逗点、H 品牌都满足国标 G≤1 的要求;
4、感观:逗点、H 品牌空白平板颜色无显著差异。
5、逗点产品需提高鼠伤寒沙门氏菌的显色,目前配方正在更新中。
三糖铁琼脂 (TSI) 验证

1、产品用途:用于鉴别肠道菌发酵蔗糖、乳糖、葡萄糖及产生硫化氢的生化反应。
2、检验原理:胨、牛肉浸出粉提供氮源、维生素、矿物质;乳糖、葡萄糖、蔗糖为可发酵糖类,其产酸时通过酚磺酞指示剂测出,酸性呈黄色,碱性呈红色;硫代硫酸钠可被某些细菌还原为硫化氢,与硫酸亚铁中的铁盐生成黑色硫化铁;氯化钠维持均衡的渗透压;琼脂是培养基的凝固剂。
3、三糖铁琼脂 (TSI) 验证
| 样品名称 |
质控菌株 |
厂家 |
待测培养基计数 |
生长率(或特征) |
评定标准 |
结果判定 |
三糖
铁琼脂
(TSI) |
大肠埃
希氏菌
ATCC25922 |
逗点 |
/ |
生长良好,A/A;产气;不产硫化氢 |
生长良好,A/A; 产气;不产硫化氢 |
符合 |
| L 品牌 |
/ |
生长良好,A/A;产气;不产硫化氢 |
符合 |
| H 品牌 |
/ |
生长良好,A/A;产气;不产硫化氢 |
符合 |
炎沙门
氏菌
CMCC(B)
50335 |
逗点 |
/ |
生长良好,K/A;产气;产硫化氢 |
生长良好,K/A; 产气;产硫化氢; |
符合 |
| L 品牌 |
/ |
生长良好,K/A;产气;产硫化氢 |
符合 |
| H 品牌 |
/ |
生长良好,K/A;产气;产硫化氢 |
符合 |
福氏志
贺氏菌
ATCC12022 |
逗点 |
/ |
生长良好,K/A;不产气;不产硫化氢 |
长良好,K/A;
不产气;不产硫化氢 |
符合 |
| L 品牌 |
/ |
生长良好,K/A;不产气;不产硫化氢 |
符合 |
| H 品牌 |
/ |
生长良好,K/A;不产气;不产硫化氢 |
符合 |
铜绿假
单胞菌
ATCC27853 |
逗点 |
/ |
生长良好,K/K;不产气;不产硫化氢 |
生长良好,K/K;
不产气;不产硫化氢 |
符合 |
| L 品牌 |
/ |
生长良好,K/K;不产气;不产硫化氢 |
符合 |
| H 品牌 |
/ |
生长良好,K/K;不产气;不产硫化氢 |
符合 |
1. 大肠埃希氏菌 ATCC25922 在三糖铁琼脂 (TSI) 上生长良好,A/A;产气;不产硫化氢;
2. 肠炎沙门氏菌 CMCC(B)50335 生长良好,K/A;产气;产硫化氢;
3. 福氏志贺氏菌 ATCC12022 生长良好,K/A;不产气;不产硫化氢;
4. 铜绿假单胞菌 ATCC27853 生长良好,K/K;不产气;不产硫化氢; |
4、典型特征图片:


5、验证结果小结:
1、生化特性:目标菌大肠埃希氏菌 ATCC25922、肠炎沙门氏菌 CMCC(B)50335、福氏志贺氏菌 ATCC12022、
铜绿假单胞菌 ATCC27853 生长特性均符合国标要求;
2、感观:逗点、L 品牌、H 品牌空白管无明显差异。
3、三家产品无明显差别,在肠炎沙门氏菌上,L 品牌更优秀 - 黑色菌更明显。